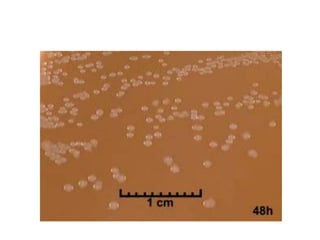
LẬU CẦU

Neisseria gonorrhoeae là mầm bệnh gây bệnh lậu, lây truyền chủ yếu qua quan hệ tình dục và có thể gây viêm niệu đạo, viêm cổ tử cung, và vô sinh. Nữ giới thường không có triệu chứng hoặc triệu chứng rất nhẹ, trong khi nam giới có tỷ lệ không triệu chứng từ 3-10%. Cách lấy bệnh phẩm và vận chuyển cần thực hiện đúng quy trình để đảm bảo độ nhạy và độ chuyên biệt trong xét nghiệm.